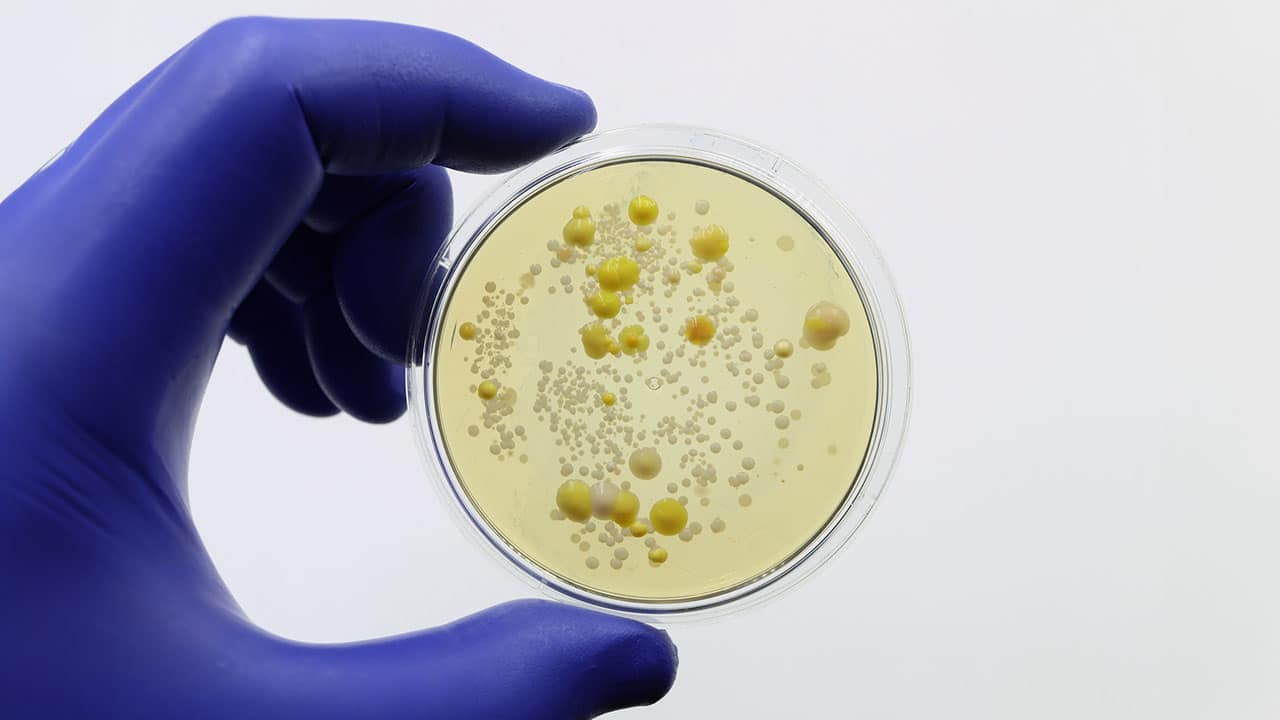

Spore Testing Is the Backbone of Dental Infection Control
Routine spore testing confirms sterilizer performance, safeguards patients, and keeps dental practices compliant with CDC and OSHA standards.
Why is spore testing considered the gold standard for sterilization monitoring in dental practices?
 nopparit / E+
nopparit / E+
According to the United States Centers for Disease Control and Prevention guidelines, how often should biological monitoring (spore testing) be performed in dental settings?
TopMicrobialStock / iStock / Getty Images Plus
TopMicrobialStock / iStock / Getty Images Plus
Which of the following is a disadvantage of mail-in spore testing compared to in-office testing?
 FreshSplash / E+
FreshSplash / E+


